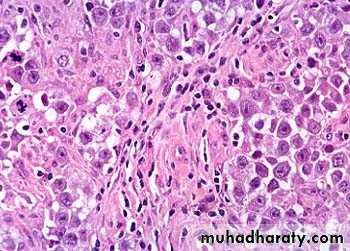

Reproductive system
Dr. Zainab .W. A. AlhayaliCollege of medicine (Ninevah)
Female Genital System
Female Genital System
Part I:Vulva, Vagina, and Cervix
1. Diseases of the Vulva
– Neoplastic2. Diseases of the Vagina
– Infectious
– Neoplastic
3. Diseases of the Cervix
– Infectious
– Non-neoplastic lesions
– Neoplasms
• Carcinoma
• Dysplasia
VULVAL TUMOURS
Benign tumors :
Condyloma Acuminatum ( Anogenital warts )
Benign papillary lesions of squamous epithelium which can be transmitted to male sex partner.Solitary but more frequently are multiple forming soft warty masses.
The common locations are the anus, perineum, vaginal wall, vulva and vagina.
They are induced by human papilloma virus (HPV), particularly types 6 and 11.
Histologically The papillary projections consist of fibrovascular stoma lined by stratified squamous epithelium with perinuclear vacuolisation called koilocytosis, indicative of HPV infection.
Condyloma acuminatum. Low-power view showing exophytic, papillary architecture.
High-power view reveals HPV cytopathic effect (koilocytic atypia) characterized by atypical, enlarged, hyperchromatic nuclei with perinuclear halos (arrow).Premalignant and Malignant Neoplasms:
• Vulvar Intraepithelial Neoplasia (VIN)• Squamous cell carcinoma
• Extra mammary Paget’s Disease of the vulva
Vulvar Intraepithelial Neoplasia (VIN)
A typical cytological changes (dysplasia) in the layers of the vulval squamous epithelium .
Graded as VIN-1, 2, or 3 (mild, moderate, severe dysplasia /carcinoma in situ or Bowen disease).
– Oncogenic HPV 16, 18 play a role in the pathogenesis .
– 50% asymptomatic• White patch (leukoplakia), sometimes red or even hyperpigmented
• May remain non-invasive for many years.
• Treatment: surgery, laser, chemicals.
VIN: Dysplasia of the vulvar epithelium, seen here at the right with overlying hyperkeratosis , with more normal keratinizing squamous epithelium at the left.
Vulval Squamous cell carcinoma
• 90% of vulvar cancers• Risk factors
– Human papilloma virus– HIV
– VIN
– Lichen sclerosus.
– History of cervical cancer
Histologically is identical to its counterparts on the skin with varying degree of anaplasia and depth of invasion .
HPV-positive tumours are more often poorly-differentiated carcinoma.
Histologically is identical to its counterparts on the skin with varying degree of anaplasia and depth of invasion at the right , with normal keratinizing squamous epithelium at the left.“Extramammary” Paget’s disease
Unique form of intraepithelial adenocarcinoma histologically indistinguishable from Paget’s disease of the nipple, this has a very different biology.–– Grossly : pruritic, red, crusted, sharply demarcated map-like areas often mistaken for inflammation clinically
–– Histologically, all tumor cells limited to epidermis.
it reveals single anaplastic tumor cells with in the epidermis. These cells are characterized by having clear spaces (“halos”) between them and the adjacent epithelial cells.
–– Prognosis excellent unless invasive cancer found.
Paget’s Disease of the VulvaDiseases of the Vagina
• Relatively rare site of significant disease– Congenital anomalies
– Infections
– Cancers
Gartner’s Duct Cysts
They are relatively common lesions found along the lateral walls of the vagina & derived from wolffian duct rests.They are 2cm fluid filled cysts that occur submucosally
Vaginal Intraepithelial Neoplasia and Squamous Cell Carcinoma
Primary carcinoma of the vagina are very uncommon1% female genital tract with 95% are sq. cell carcinoma.
Secondary spread from adjacent sites are more common.
Pathology of the Uterus
Pathology of the Uterus
• Cervix• Endometrium
• Myometrium
Cervix
• Infections– cervicitis
– Any vaginitis will also involve cervix
• Non-neoplastic lesions
– Squamous metaplasia– Nabothian Cysts
– Cervical polyp
• Neoplasms
– Dysplasia
– Cancer
Cervicitis
Definition : inflammation of the cervical mucosa.Many cervical infections are of a non-specific and probably mixed bacterial nature.
Specific infections with Neisseria gonorrhea , Herpes virus ,Chlamydia , Mycobacteria ,Trichomonas vaginalis & Treponema pallidum
chronic cervicitis:
Small round dark lymphocytes are seen in the submucosa, and there is also hemorrhage.CERVICAL POLYPS
localized benign proliferations of endocervical mucosa though they may protrude through the external os.Found in 2-5% of adult women and produce irregular vaginal spotting.
Grossly: small (up to 5 cm in size), bright red, fragile growth which is frequently pedunculated but may be sessile.
Microscopically :most cervical polyps are endocervical polyps and are covered with endocervical epithelium which may show squamous metaplasia.
Endocervical polyp composed of a dense fibrous stroma covered with endocervical columnar epithelium.
Squamous Metaplasia
• Process by which endocervical mucinous columnar epithelium changes to squamous epithelium.• This area of sq. metaplasia is often known as the “Transformation Zone” and it is of considerable importance because it is the site of cervical dysplasias and cancers.
Before puberty
At pubertyAfter puberty and pregnancy
At menopause
Immature
squamousCells
Squamocolumnar
JunctionColumnar
glandularcells
Mature squamous cells
CERVICAL INTRAEPITHELIAL NEOPLASIA (CIN).
DYSPLASIA This term has been commonly used for atypical cytological changes in the layers of squamous epithelium, the changes being progressive.
Depending upon the thickness of squamous epithelium involved by atypical cells, dysplasia is conventionally graded as mild, moderate and severe.
Carcinoma in situ is the full-thickness involvement by atypical cells, or in other words carcinoma confined to layers above the basement membrane.
CIN An alternative classification is to group various grades of dysplasia and carcinoma in situ together into cervical intraepithelial neoplasia (CIN) which is similarly graded from grade I to III.
Cervical Dysplasia
Normal CIN I CIN II CIN III
SIL Currently, the three grades of CIN are readjusted into two grades of squamous intraepithelial lesions (SIL)—Low-grade SIL (L-SIL)
—High-grade SIL (H-SIL)
Many cases of CIN either remain stationary or regress with probably no more than 1/3 of cases of CIN III advancing to invasive stage .
All cases of CIN have to be regarded as potentially invasive ,fortunately these epithelial lesions , though asymptomatic are readily detected by cytological examination of the cervical smear preparations (Pap smear)
Treatment & eradication by techniques such as cryocautory & laser therapy are relatively simple.
Pap smear is by far the most effective cancer screening and prevention technique in use
Cervical cancerRisk factors
1) Early age of sexual activity.2) Family history of cervical cancer
• HPV infection with high-risk types of oncogenic virus.
• Weakened immune system
• Socio-economic status
• Oral contraceptives
• Potential role of high risk male sexual partner having history of penile condyloma and those lack of circumcision
Grossly : Invasive cervical carcinoma may present 3 types of patterns: fungating, ulcerating and infiltrating.
Microscopically: The following patterns are seen:
1. Squamous cell carcinoma This type comprises vast majority of invasive cervical carcinomas (about 70%).
2. Adenocarcinoma Adenocarcinomas comprise about 20-25% of cases.
3. Others The remaining 5% cases are a variety of other patterns such as adenosquamous carcinoma .
Cervical cancerArose in squamocolumnar junction
Squamous cell carcinoma of the cervix
Female Genital SystemPart II:
Endometrium and Myometrium
– Infectious
– Non-neoplastic lesions– Neoplasms
NORMAL STRUCTURE
The myometrium is the thick muscular wall of the uterus which is covered internally by uterine mucosa called the endometrium.
The endometrium is relatively resistant to infection ,partly because of it’s excellent natural drainage & partly because it is difficult for an infection to become established during reproductive life in a tissue which is regularly shed .
Acute Endometritis
most commonly after an abortion especially if fragments of the placenta or membrane are retained in the uterus .A variety of organisms including streptococci ,staph. ,E.coli & pseudomonas .
The inflamed endometrium is edematous & congested with polymorphnuclear cells infiltrate not only in stroma but also in the glands where small intra luminal abscesses are commonly seen.
There are scattered neutrophils in glands and stroma, indicative of acute endometritis
Chronic non-specific endometritis
may follow an acute endometritis but is more commonly chronic from the onset.chronic inflammatory cells infiltration with predominance of plasma cells ,some degree of fibroblastic & vascular proliferation may be present
Tuberculous Endometritis
It is nearly always secondary to tuberculous salpingitis .The disease is often accompanied by infertility
Continued menstrual shedding of the endometrium prevent the disease proceeding to the caseation
Tuberculous Endometritis
ENDOMETRIAL POLYPS
clinical term used for a polypoid growth projecting into theuterine lumen
They are more common in the perimenopausal age group.
single or multiple, usually sessile and small but occasionally they are large and pedunculated.
They are essentially made up of mixture of endometrial glands and stroma. The histologic pattern of the endometrial tissue in the polyp may resemble either functioning endometrium or hyperplastic endometrium of cystic hyperplasia type, the latter being more common.
Endometrial hyperplasia
Definition: exaggerated proliferation of glandular and stromal tissues.Presentation: prolonged, profuse and irregular uterine bleeding .
Etiology : abnormally high ,prolonged level of estrogenic stimulation with diminution or absence of progestational activity .
occurs most commonly around menopause or in association with persistent an ovulation in younger women
clinically significant because it is closely linked to endometrial carcinoma.
Causes:
Endometrial hyperplasia develops when estrogen and progesterone, are out of balance, and the endometrium is exposed to somewhat more estrogen than progesterone. This is called unopposed estrogen. Several things can cause this imbalance, including:
• 1. High level of endogenous estrogen.
• - Obesity-Polycystic ovarian disease
(Stein Leventhal syndrome ).
-Functioning granulose cell tumors of the ovary.
-Excessive cortical function (cortical stromal hyperplasia ).
2. Exogenous estrogen
- Estrogen-only hormone replacement therapy (HRT)- Tamoxifen (Nolvadex, Tamofen) given to treat breast cancer
Classification
1. Simple hyperplasia without atypia (Cystic glandular hyperplasia).Simple patterns of increase in the gland-to-stroma ratio.
The glands show variation in size and shape and may be dilated but still stroma in between.
No cellular atypia.
rarely progress to adenocarcinoma ( 1% to 3%).
2. Complex hyperplasia
• without atypia (Complex nonatypical hyperplasia).
• with atypia (Complex atypical hyperplasia).
complex patterns of proliferating glands.
The glands are commonly back-toback and often have complex outlines due to branching structures.
Cells may ormay not displaying nuclear atypia
- 23% to 48% of atypical hyperplasia can progress to carcinoma.
Simple hyperplasia without atypia
Complex hyperplasia with atypia
Endometrial carcinomaThe most common invasive cancer of the female genital tract.
Pathogenesis:
Clinicopathologic studies and molecular analyses support the classification of endometrial carcinoma into two broad categories referred to as type I and type IIType I (Endometrial) Carcinoma.
These are the most common type, accounting for approximately 80% of cases.
Most are well differentiated carcinoma.
they typically arise in the setting of endometrial hyperplasia.
Type II Carcinoma.
These generally occur in women who are about 10 years older than those with type I carcinomasthey are poorly differentiated tumors and account for approximately 15% of cases of endometrial carcinoma.
They usually arise in the setting of endometrial atrophy
Uterus : well differentiated endometrial carcinoma
EndometriosisDefinition: presence of endometrial glands and stroma in abnormal locations outside the uterus.
The ectopic tissue occurs most commonly in the ovaries ,fallopian tubes ,pouch of Douglas , uterine ligaments ,recto vaginal septum & the bowel . Occasionally foci of endometriosis are encountered in laparotomy scar , at the umbilicus or in the skin .
Histogenesis of endometriosis
The following 3 theories are described:1. Transplantation or regurgitation theory is based on the
assumption that ectopic endometrial tissue is transplanted
from the uterus to an abnormal location by way of fallopian
tubes due to regurgitation of menstrual blood.
2. Metaplastic theory suggests that ectopic endometrium
develops in situ from local tissues by metaplasia of the coelomic
epithelium.
3. Vascular or lymphatic dissemination explains the development of endometrial tissue at extra pelvic sites by these routes.
MORPHOLOGIC FEATURES
Grossly, typically, appear as blue or brownish-black underneath the surface of the sites mentioned. Often, these foci are surrounded by fibrous tissue resulting in adherence to adjacent structures.The ovary is the most common site of endometriosis and shows numerous cysts varying in diameter filled with old dark brown blood form ‘chocolate cysts’ of the ovary.
Histologically, the diagnosis is simple and rests on identification of foci of endometrial glands and stroma, old or new haemorrhages, haemosiderin-laden macrophages and surrounding zone of inflammation and fibrosis
Endometriosis : small cluster of endometrial glands and stroma with hemorrhage are seen at the left near the surface of the fallopian tube. The lumen of the tube is at the right.
Adenomyosis
Definition: the presence of endometrial tissue with in the myometrium , below the base of the endometrium.
The cause is unknown ,it occurs in approximately 15 to 20 % of the uteri. Adenomyosis causes expansion (enlargement ) of the uterine wall & may be visible on gross examination as numerous small cysts .
Microscopically
Irregular nests of endometrial stroma ,with or without glands ,are arranged with in the myometrium with myometrial muscle reaction around it separated from the basalis by at least 2 to 3 mm.
Benign tumors
LeiomyomasOrigin: from the smooth muscle cells of the myometrium.
usually multiple extremely common & vary in size from tiny seeding less than 1 cm in diameter to huge masses which fill the abdomen .
Site: within the wall i.e. intramural , immediately below the endometrium a submucosal ,or lie just beneath the peritoneum to form a subserosal tumor .
Malignant tumors
Myometrial leiomyosarcomasrare ,arise either in a pre-existing leiomyoma or directly from the myometrium .
They are less well demarcated in appearance than leiomyomas often show areas of haemorrhage or necrosis & are characterized histologically by their cellularity ,pleomorphism& mitotic activity ( i.e. 10 or more than 10 mitosis per 10 high power fields ).
leiomyosarcoma occur most commonly during the sixth decade & have a poor prognosis .
Gestational Trophoblastic Disease
Gestational trophoblastic disease comprises a heterogeneous group of lesions arising from abnormal proliferation of trophoblast of the placenta.Classification of Gestational trophoblastic disease :
1. hydatidiform mole• Complete
• partial .
• invasive.
2 placental site trophoblastic tumor.
3 choriocarcinoma .
(Hydatidiform Mole )
Complete H. mole.
This is an abnormal conceptus in which an embryo is absent and the placental villi are so distended by fluid that they resemble a bunch of grapes .
women with a mole has a 2-3% risk of eventually developing choriocarcinoma
Microscopically :
The stroma of the villi is markedly edematous often with cistern formation .A constant feature is the presence o f a variable degree of atypical villous trophoblastic hyperplasia
Complete H .Mole is caused by abnormal gametogenesis & fertilization .
The nuclei of the trophoblastic cells in this disease contain only paternal chromosomes & are therefore androgenetic in origin .Chromosomes are diploid 46,XX in 90% cases 46,XY in a small part
Partial H.Mole
About 15 - 35% of all moles are of the partial type.
It is often associated with the presence of an embryo although is usually abnormal.
The risk for the development of choriocarcinoma following a partial mole is very low.5 -10 % of partial mole progress to invasive mole
Grossly:The placenta contain mixture of normal & vesicular villi .These villi show focal edema leading to central “cisternal” formation .Many of the villi contain fetal (nucleated ) red blood cells .
Trophoblastic proliferation is present but in lesser degree than in complete H. mole .
Most partial moles are triploid (69xxx or 69xxy) & few show trisomy 16.
A partial mole is often accompanied
by a fetus that is usually grossly abnormal .
Pathogenesis of molar pregnancy
Invasive Mole
It refers to H.M. ( nearly always of the complete type but occasionally of the partial type ) in which the villi penetrate the myometrium &/or its blood vessels .This phenomenon which occur in 17% of all complete moles , it is an exaggerated expression of the capacity of normal trophoblast for invasion .
Invasive mole : hydropic villi within the myomatrium
Choriocarcinoma
It is a malignant tumor of trophoblast & is formed of both cytotrophoblast & syncytiotrophoblast.It is a unique neoplasm in that being purely fetal origin .
It is neoplastic allograft in the mother .
The tumor follows H.mole in 50% of cases & unremarkable abortion in a further 25% ;the remainder develop often after a period of months or years ,as a sequel to an apparently normal pregnancy .
Choriocarcinoma & H.mole secrete placental HCG & assay of serum & urinary levels of this tumor marker are used in patient management .
There is increased risk of choriocarcinoma for women of group A married to men of the same group .
Microscopically :
The tumor is composed of cluster of cytotrophoblast separated by streaming masses of syncytiotrophoblast ,resulting in a characteristic dimorphic plexiform pattern .Villi are characteristically absent as a matter of fact ,their presence is said to rule out the diagnosis of choriocarcinoma .No matter how atypical the trophoblastic cells may be .
The natural history of untreated choriocarcinoma is characterized by the development of early hematogenous metastasis ,the most common sites being the lung, vagina, brain, liver, kidney &bowel & often present with massive hemorrhage .
Ovary
Classification of ovarian tumors
• A simplified form of the classification of ovarian tumors in to 5 groups :• I- Tumors derived from the surface epithelium(60% of all ovarian tumors):
• 1-Serous tumors ( benign ,border line ,malignant ).
• 2-Mucinous tumors (= , = , = ).
• 3-Endometriod tumors (= ,= , = ).
• 4-Clear cell tumors ( = , = , = ) .
• 5-Transitional cell tumors ( Brenner tumor of benign border line & malignant Brenner tumor).
• II-Tumors of sex cord & stromal origins
• 1-Granulosa –stromal cell tumors, leading to granulosa cell tumors ,tumors of the thecoma –fibroma group .• 2-Sertoli-stromal cell tumors ; androblastoma.
• 3-Sex cord tumor with annular tubules .
• 4-Gynandroblastoma .
• 5-Steroid (lipid) cell tumors .
• III-Tumors derived from the germ cells
• 1-Teratoma• 2-Dysgerminoma identical to seminoma of testis .
• 3-Yolk sac tumor ( endodermal sinus tumor).
• 4-Mixed germ cell tumor.
Dermoid cyst containing tooth, cartilage & hair
• IV-Miscellaneous tumors
• Primary lymphoma of the ovary .• V-Metastatic tumors
• The ovary is a common site of secondary tumors especially from the uterus ,breast & GIT.• Krukenberg tumor :
• it is secondary tumor in the ovaries which is due to transcoelomic spread of a gastric or colonic adenocarcinoma & is characterized by the presence of mucin –containing signet ring cells scattered in a fibrous stroma which is extremely cellular .
Male reproductive system
prostate
Normal weights approximately 20 gm.Its a retroperitoneal organ.
consist of 5 lobes: posterior, middle, anterior & 2 lateral lobes.
Histology: it composed of 2 element
Glandular element of large size lined by 2 cell layers.Fibro muscular stroma.
prostate
Inflammation.Nodular prostatic hyperplasia.
Prostatic carcinoma.
Inflammation
1- Acute bacterial prostatitis:
Acute focal or diffuse suppurative inflammation.
caused by various strains of E. coli, enterococci, gram negative rods & staphylococci.
The m.o. become implanted in the prostate usually by intraprostatic reflux of urine from the posterior urethra, or by the lymphohematogenous routes from distant foci of infection.
It may follow some surgical manipulations of the urethra or the prostate itself.
Diagnosis : by clinical features &urine culture.
2- Chronic bacterial prostatitis:
low back pain, dysuria, perineal & suprapubic discomfort.Common historical characteristic is recurrent UTI (cystitis & urethritis) caused by same organism.
Diagnosis: leukocytosis in the expressed prostatic secretion with positive bacterial culture of the secretion also.
3- Chronic a bacterial prostatitis ( Lymphocytic Prostatitis).
Most common type now a days.No history of recurrent UTI. Culture negative.
Caused by sexual transmitted pathogens e.g., C. trachomatis, Ureaplasma urealyticum & mycoplasm.
Micro: It should be differentiate from chronic lymphocytic leukemia.
Nodular prostatic hyperplasia
Extremely common disorder in men above 50 yr. Its regarded as normal aging process.Hyperplasia of both prostatic stroma & epithelial cells.
It occurs in periurethral region so caused partial or complete obstruction of urethra.
Pathogenesis:
The cause of NPH is Unknown
Dihydrotestosteron (DHT) a metabolite of testosterone act on nuclear androgen receptor on stromal & epithelial cells signals a transcription of a growth factors stimulate proliferation & growth.
Estadiol (estrogen) level increase in elderly person which increase nuclear androgen receptor & possibly sensitize the prostate to the growth- promoting effects of DHT.
Nodular prostatic hyperplasia
Grossly: increase weight of prostate (60-100 gm) with gray-white firm nodules affecting periurethral & transitional zones.
Histology: The earliest changes is a stromal proliferation in the periurethral portion of the prostate, this followed by glandular proliferation .
Some glands are dilated or even cystic & often contain an inspissated secretion of glycoprotein nature (corpora amylacea) which is some times calcified.
Foci of squamous metaplasia & small areas of infarction some times are seen.
It is not a premalignant lesion
Presentation: Difficulty in urination & retention of urine, cystitis, UTI and renal stones.
105
well circumscribed, white-tan, rubbery hyperplastic nodules on either side of the compressed urethra
nodule composed of crowded, hyperplastic glands. Note the well-circumscribed margin of the process in the upper right hand corner. Also note the two-cell-layer epithelium characteristic of benign prostatic glands.
Prostatic carcinoma
Most common form of cancer in men, Followed closely by lung cancer.
Second leading cause of cancer death.
Etiology:
Several risk factors e.g. age, race, family history, hormone levels (testosterone & androgen) & environmental influences are suspected of playing roles.Increased consumption of fats has been implicated, its influences the levels of hormones such as testosterone, which in turn affect the growth of prostate.
Prostatic carcinoma
Grossly: affecting peripheral zone of the gland classically in the posterior location.firm yellow with gritty cut section
Histology: small closely packed glands (back-to-back) with single cell lining. These cells have large vesicular nuclei with prominent one or more nucleoli .Invasion of capsule with its lymphatic & vascular channels, perineural invasion or both.
110
Prostatic adenocarcinoma can display several architectural arrangements, including back-to-back small neoplastic glands and coalesced, or fused, glands forming cribriform patterns
111
Malignant prostatic glands are lined by a single layer of cells that typically display large nucleoli (as opposed to a two-cell layer without large nucleoli in benign glands)
Prostatic carcinoma
Clinical course:60 % of patient presented with localized disease in the prostatic gland.
40 % of patient presented with invasion to the surrounded organ specially urinary bladder & tract causing urinary symptoms or metastases by lymphatic to the obturator lymph nodes.
Or metastasis by blood to the axial skeleton especially to lumber spine, pelvis & thoracic spine producing osteoblastic reaction.
Penis
Congenital anomalies.
Tumors.
Congenital anomalies
Hypospadias & EpispadiasMalformation of urethral groove & canal.
Create abnormal opening either on the ventral surface of the penis (hypospadias) or the dorsal surface (epispadias)
Hypospadias more common.
May associated with undescended testis
Complication: 1- UTI.
2-UT obstruction.
3- Abnormal ejaculation.
Phimosis
When the orifice of prepuce is too small to permit its normal retraction.Result in interference with cleanliness & accumulation of secretion under the prepuce.
causes repeated attack of secondary infection.
Complication:
may result in tumor development.Carcinoma In Situ
Epithelial lesions having cytological changes of malignancy confined to the epithelium with no evidence of local invasion or distal metastases.
3 types
Bowens disease.Erythroplagia of Queyrat.
Bowenoid papulosis.
Bowens Disease
Occurs in age over 15 years.Strong association with HPV 16 & 18 ( 80 %).
Occurs in skin of shaft of penis & scrotum.
Grossly: plaque with shallow ulceration & crusting.
Histology: proliferation of epidermis with numerous mitosis & lack of orderly maturation. Cell are dysplastic with hyper chromatic nuclei.
10 % change to invasive squamous cell carcinoma .
Erythroplagia of Queyrat
Occurs on the glans & prepuce.Grossly: single or multiple, shiny red velvety plaque.
Histology: as in Bowens disease.
Bowenoid papulosis
Sexually active young men (mean age 30), usually on skin of shaft, glans or scrotum.Associated with HPV 16 or 18.
Almost never becomes invasive.
May spontaneously regress.
Gross: multiple, small, pigmented papular lesions, may resemble condyloma accuminatum.
Micro: histologically resembles Bowen’s disease, but may have mild / heavy melanin pigmentation within the lesion; often spiky or flat appearance, may have less cytological atypia .
Squamous cell carcinoma
Occurs between 40 - 70 years.10 - 20 % of male malignancies in some parts of Asia, Africa & south America.
Circumcision confers protection so it is rare in Moslems & Jews.
50 % of cases associated with HPV 16 & 18
Cigarette smoking is another risk factor.
Squamous cell carcinoma
Commonly occurs in glans or inner surface of the prepuce near the coronal sulcus.Grossly: either papillary or ulcerated lesion.
Histology: invasion of nest of squamous cell of varying degree of differentiation with desmoplasia & inflammation.
It is slowly growing tumor with early metastasis to the inquinal lymph node.
Testes & epididymis
Congenital anomalies.Inflammations.
Tumors.
Congenital anomalies
Cryptorchidism (Undescended Testis)Found in approximately 1 % of 1 year-old boys.
complete or incomplete failure of the intra abdominal testis to descend to the scrotal sac.
Normally 2 phases
transabdominal: from abdomen to the brim of the pelvis controlled by hormone (Mullerian-inhibitor substance)
inguinoscrotal: controlled by androgen hormone from genitofemoral nerve.
Transabdominal defect is uncommon (5-10%).
Majority in inguinal canal.
May associated with other anomalies.
Cryptorchidism (Undescended Testis)
Most common unilateral but in 25 % bilateral.
Histological changes occurs as early as 2 years of age.
Bilateral cases may result into sterility.
Five folds to ten folds increase in testicular tumor in un descended.
Inflammation
More common in epididymis than in testisFour major specific types
Gonorrhea.
T.B. (mostly involve the epididymis).
Mumps.
Syphilis (affect first the testis).
Testicular tumors
Divided into 2 major categoriesGerm cell tumor (95 %).
Non Germ cell tumor derived from stroma or sex cord.
Most Germ cell tumors are highly aggressive cancer capable of rapid wide dissemination.
Germ cell tumors
Age affected between 15-34 years. In this age group they constitute the most common tumor in male & account approximately 10 % of all cancer death.Much more common in whites than in blacks in ratio of 5:1.
Divided into 2 categories:
Seminoma (usually pure 40 %)
Non seminomatous (usually mixed 60 %) these are:
Embryonal carcinoma
yolk sac tumor
Teratoma
Choriocarcinoma
Germ cell tumors
PathogenesisSeveral influences may be important
1-Cryptorchidism: 10 % of testicular tumor associated with undescended testis.
2-Genetic predisposition:
blacks more affected than whites.
familial clustering (10 folds increase risk in close relative).
Isochromosome 12 (i 12p) are found commonly.
3-Testicular dysgenesis: testicular feminization & klinefilter syndrome increase risk.
Seminoma
Divided intoClassical (85 %).
Anaplastic (5-10 %).
Spermatocytic seminoma (4-6 %).
Grossly: homogenous, gray-white, lobulated cut surface devoid from necrosis & hemorrhage.
Histology: sheets of uniform cell with clear cytoplasm contain glycogen with infrequent mitosis these cells arrange in poorly demarcated lobules by delicate septa of fibrous tissue contain T-lymphocytes.
134
sheets of uniform polygonal cells with clear cytoplasm, round nuclei, and prominent nucleoli. Typically, the cells are divided into ill-defined nodules by fibrous trabeculae containing lymphocytes.
135
The clear cytoplasm, round nucleus, and prominent nucleoli of the seminoma cells are best seen at high power. Note the fibrous trabeculae infiltrated with lymphocytes
Embryonal carcinoma
More aggressive than seminoma.Grossly: small, variegated poorly demarcated at the margin with foci of necrosis & hemorrhage.
Histology: sheets of large anaplastic, angry-looking cells with high mitotic count grow in glandular or alveolar or tubular pattern.
Yolk sac Tumor (endodermal sinus tumor)
Most common testicular tumor in infants& children up to 3 years of age with very good prognosis.In adult usually occurs in combination with embyronal carcinoma with bad prognosis.
Grossly: homogenous, yellow-white, mucinous appearance
Histology: lacelike network of cuboidal cells with Schiller-Duval bodies (glomeruli-like structure), with central capillary & mesodermal core.
Cell contains eosinophilic, hyaline-like globules in which AFP can be demonstrated.
Schiller-Duval bodies (glomeruli-like structure), with central capillary & mesodermal core.
Choriocarcinoma
Highly malignant form of testicular tumor that is composed of both cytotrophoblast & sycytotrophoblastcommonly occurs in mixture with other germ cell tumors.
Grossly: small nodule with foci of hemorrhage & necrosis, rapidly growing.
Secrete HCG
Histology: mixture of syncytotrophoblast (large cell with many irregular hyper chromatic nuclei & abundant eosinophilic cytoplasm which is + ve for HGC) & trophoblast (polygonal cell with clear cytoplasm & single uniform nucleus).
Teratoma
Group of complex tumor derived from more than one germ cell layer.pure form are fairly common in infant & children.
In adults occur in combination with other Germ cell tumor mostly embryonal carcinoma.
Grossly: heterogeneous large mass with solid sometime cartilaginous & cystic areas.
Histology: 3 types
1- Mature teratoma: different type of mature tissue e.g., neural, muscle, cartilage, bits of intestinal wall, bronchial epithelium, thyroid, skin...
2- Immature teratoma: elements of 3 germ layers but incompletely differentiated e.g., poorly formed cartilage, neuroblasts, loose mesenchyme & cluster of glandular structure. They consider as malignant variant.
3- Teratoma with malignant transformation: focus of clear cut squamous cell ca, adenocarcinoma, carcinoid or sarcoma.
Tumors of sex cord-gonadal stroma
Two main typesLeydig cell tumor.
Sertoli cell tumor.
Leydig cell tumor
Occurs between 20-60 years of age.
common presenting features are testicular swelling, gynecomastia & sexual precocity in children.
Tumor elaborate androgens or androgen & estrogens.
Most are benign. Only 10 % invasive
Grossly: homogenous golden brown circumscribed nodule
Histology: polygonal cell with abundant granular eosinophilic cytoplasm with lipofuscin pigment & rod-shaped Reinke crystalloids.
Sertoli cell tumor
Same age group as Leydig cell tumor.May composed entirely of Sertoli cells or may have a component of granulosa cells.
Some induced endocrinologic changes, either androgen or estrogen may be elaborated.
Most are benign but 10 % are malignant.
Grossly: firm small nodule with homogenous gray-white to yellow cut surface.
Histology: uniform cells arrange in cord-like structures resembling immature seminiferous tubules.